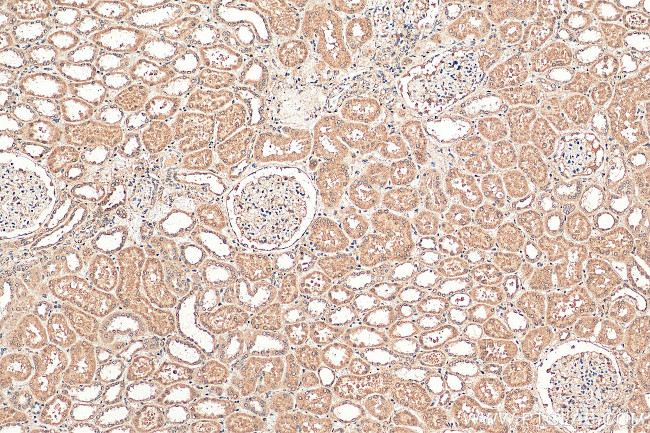
PARP11 Antibody in Immunohistochemistry (Paraffin) (IHC (P))

Search
Proteintech
PARP11 Polyclonal Antibody
{{$productOrderCtrl.translations['antibody.pdp.commerceCard.promotion.promotions']}}
{{$productOrderCtrl.translations['antibody.pdp.commerceCard.promotion.viewpromo']}}
{{$productOrderCtrl.translations['antibody.pdp.commerceCard.promotion.promocode']}}: {{promo.promoCode}} {{promo.promoTitle}} {{promo.promoDescription}}. {{$productOrderCtrl.translations['antibody.pdp.commerceCard.promotion.learnmore']}}
产品信息
16692-1-AP
种属反应
宿主/亚型
分类
类型
抗原
偶联物
形式
浓度
规格
纯化类型
保存液
内含物
保存条件
运输条件
产品详细信息
Immunogen sequence: MFHKAEELF SKTTNNEVDD MDTSDTQWGW FYLAECGKWH MFQPDTNSQC SVSSEDIEKS FKTNPCGSIS FTTSKFSYKI DFAEMKQMNL TTGKQRLIKR APFSISAFSY ICENEAIPMP PHWENVNTQV PYQLIPLHNQ THEYNEVANL FGKTMDRNRI KRIQRIQNLD LWEFFCRKKA QLKKKRGVPQ INEQMLFHGT SSEFVEAICI HNFDWRINGI HGAVFGKGTY FARDAAYSSR FCKDDIKHGN TFQIHGVSLQ QRHLFRTYKS MFLARVLIGD YINGDSKYMR PPSKDGSYVN LYDSCVDDTW NPKIFVVFDA NQIYPEYLID FH (1-331 aa encoded by BC017569)
靶标信息
Mono-ADP-ribosyltransferase that mediates mono-ADP-ribosylation of target proteins (PubMed:25043379, PubMed:25673562). Plays a role in nuclear envelope stability and nuclear remodeling during spermiogenesis. [UniProt]
仅用于科研。不用于诊断过程。未经明确授权不得转售。
篇参考文献 (0)
生物信息学
蛋白别名: ADP-ribosyltransferase diphtheria toxin-like 11; ARTD11; PARP-11; Poly [ADP-ribose] polymerase 11; Protein mono-ADP-ribosyltransferase PARP11; unnamed protein product
基因别名: 5330431N24Rik; AI851877; ARTD11; C12orf6; HIN1L; MIB006; PARP11
UniProt ID: (Human) Q9NR21, (Mouse) Q8CFF0
Entrez Gene ID: (Human) 57097, (Mouse) 101187